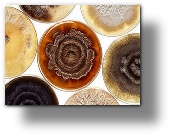

|
|

Molds
Absidia spp.
Algae
Alternaria tenuis (alternata)
Aspergillus flavus
Aspergillus fumigatus
Aspergillus nidulans
Aspergillus niger
Aspergillus terreus
Aspergillus versicolor
Aureobasidium pullulans
Bipolaris specifera
Botrytis cinerea
Candida albicans
Cephalosporium acremonium
Chaetomium globosum
Cladosporium cladosporoides
Cladosporium herbarum
Curvularia lunata
Epicoccum purpurascens
Epidermophyton flocossum
Fusarium moniliforme
Fusarium oxysporum
Geotrichum candidum
Helminthosporium halodes
Helminthosporium interseminatum
Helminthsporium sativum
Helminthsporium solani
Hormodendrum hordei
Absidia spp.
Algae
Alternaria tenuis (alternata)
Aspergillus flavus
Aspergillus fumigatus
Aspergillus nidulans
Aspergillus niger
Aspergillus terreus
Aspergillus versicolor
Aureobasidium pullulans
Bipolaris specifera
Botrytis cinerea
Candida albicans
Cephalosporium acremonium
Chaetomium globosum
Cladosporium cladosporoides
Cladosporium herbarum
Curvularia lunata
Epicoccum purpurascens
Epidermophyton flocossum
Fusarium moniliforme
Fusarium oxysporum
Geotrichum candidum
Helminthosporium halodes
Helminthosporium interseminatum
Helminthsporium sativum
Helminthsporium solani
Hormodendrum hordei
Molds (con't)
Microspora canis
Mold Mix
Mucor mucedo
Mucor plumbeus
Mucor racemosus
Nigraspora oryzae
Penicillium notatum
Phoma betae
Phoma herbarum
Rhizopus nigricans
Rhodoturula mucilaginosa
Smut, Bermuda Grass
Smut, Corn
Smut, Johnson Grass
Smut, Wheat
Stachybotrys chartarum
Stemphylium botryosum
Stemphylium solani
T.O.E.
Trichoderma lignorum/viride
Trichophyton mentagrophytae
Trichophyton rubrum
Microspora canis
Mold Mix
Mucor mucedo
Mucor plumbeus
Mucor racemosus
Nigraspora oryzae
Penicillium notatum
Phoma betae
Phoma herbarum
Rhizopus nigricans
Rhodoturula mucilaginosa
Smut, Bermuda Grass
Smut, Corn
Smut, Johnson Grass
Smut, Wheat
Stachybotrys chartarum
Stemphylium botryosum
Stemphylium solani
T.O.E.
Trichoderma lignorum/viride
Trichophyton mentagrophytae
Trichophyton rubrum
Tel 615-599-4100 * Fax 615-599-4648 * Toll Free 877-992-4100
improving allergy outcomes



